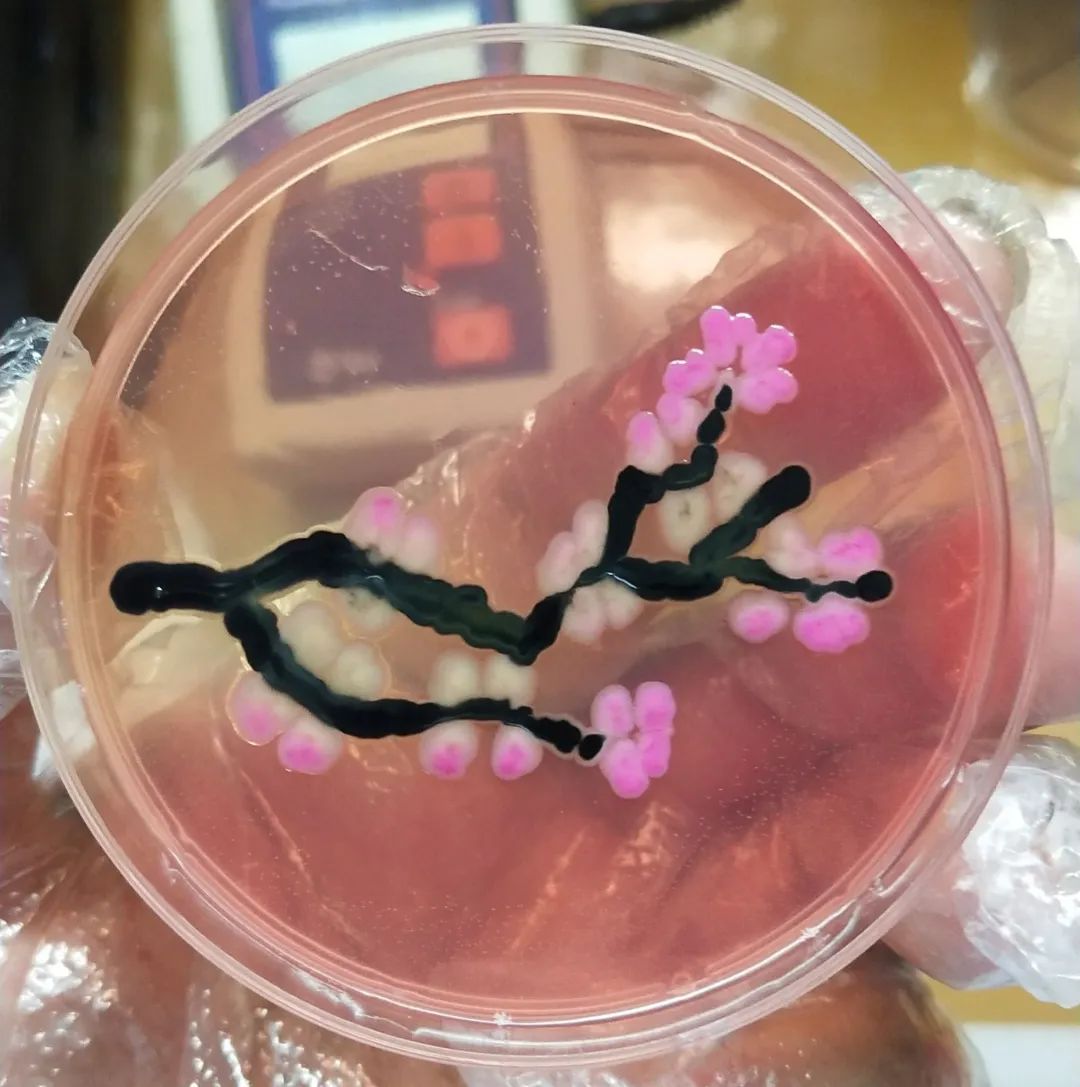

为深入贯彻中共中央办公厅《关于加强新时代廉洁文化建设的意见》和省、市有关精神,按照县委《关于推进清廉府谷建设的意见》以及关于开展“转作风、树形象、优环境、促发展”专题年活动和廉洁文化建设的部署要求,府谷县纪委监委会同县委组织部、县委宣传部联合举办“清廉府谷”廉洁文化艺术作品有奖征集活动,动员全社会共同营造崇尚廉洁、倡导廉洁、践行廉洁的浓厚氛围,共建政治清明、政府清廉、干部清正、社会清朗、文化清新的“清廉府谷”。此项活动开展以来,全县广大干部群众和社会各界人士积极支持、踊跃参与,已征集廉洁文化艺术作品600余件,投稿作品将首先通过“清廉府谷”微信公众号分批线上展示,经评选产生的优秀作品将举办线下巡展。
摄 影 作 品

《我与国旗合影 我为祖国祝福 》
韩林霞
府谷县第五幼儿园

《听党话 感党恩 跟党走》
韩敏
府谷县第七幼儿园

《丰收的喜悦》
李慧东
府谷县融媒体中心

《府谷海红果香溢四方》
丁晓霞
府谷县林业局

《农家乐》
苏曦
府谷县退休干部

《盼》
王永强
府谷县教体局

《清洁者的早晨》
苏曦
府谷县退休干部

《最美抗议者》
苏怡凡
府谷县第二中学

《责任》
段文林
府谷县融媒体中心

《好样的》
刘利
府谷县教体局

《铸梦的》
丁晓霞
府谷县林业局

《能源大道》
刘思瑜
府谷县第二中学

《初冬黄河美如画》
刘北卿
府谷县融媒体中心

《守望》
高永泽
府谷县纪委监委
注:该作品是以沙门氏菌为枝干,大肠埃希菌为花朵,以培养皿为布,微生物为笔,勾勒出的一朵高洁傲岸的梅花。
《梅花》
柴小飞
府谷县人民医院